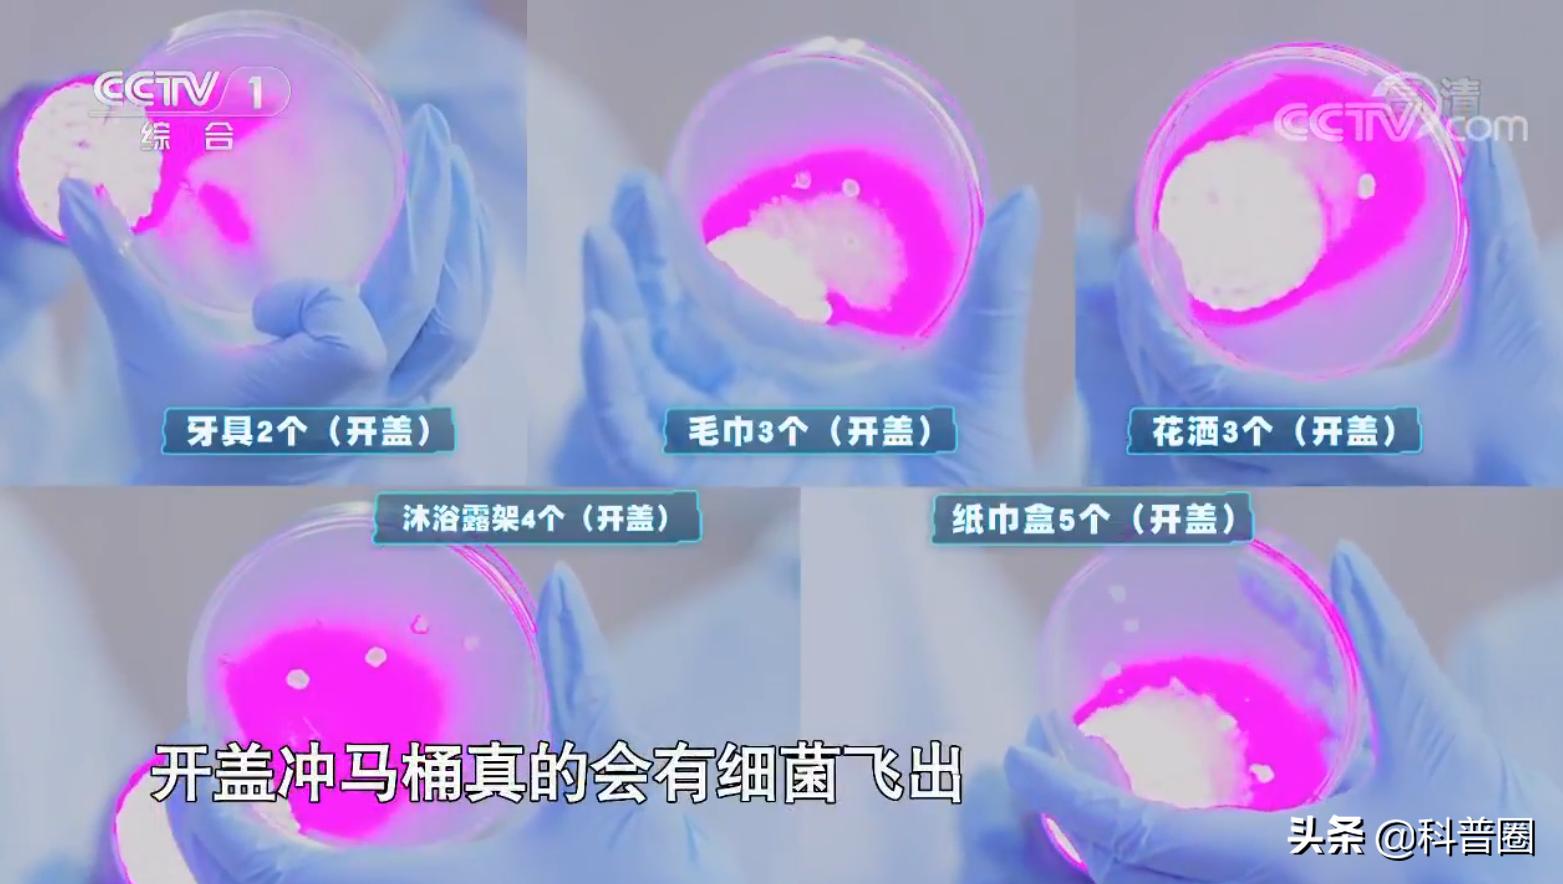
冲马桶时要不要盖盖子央视辟谣,冲马桶盖盖子和不盖盖子对比
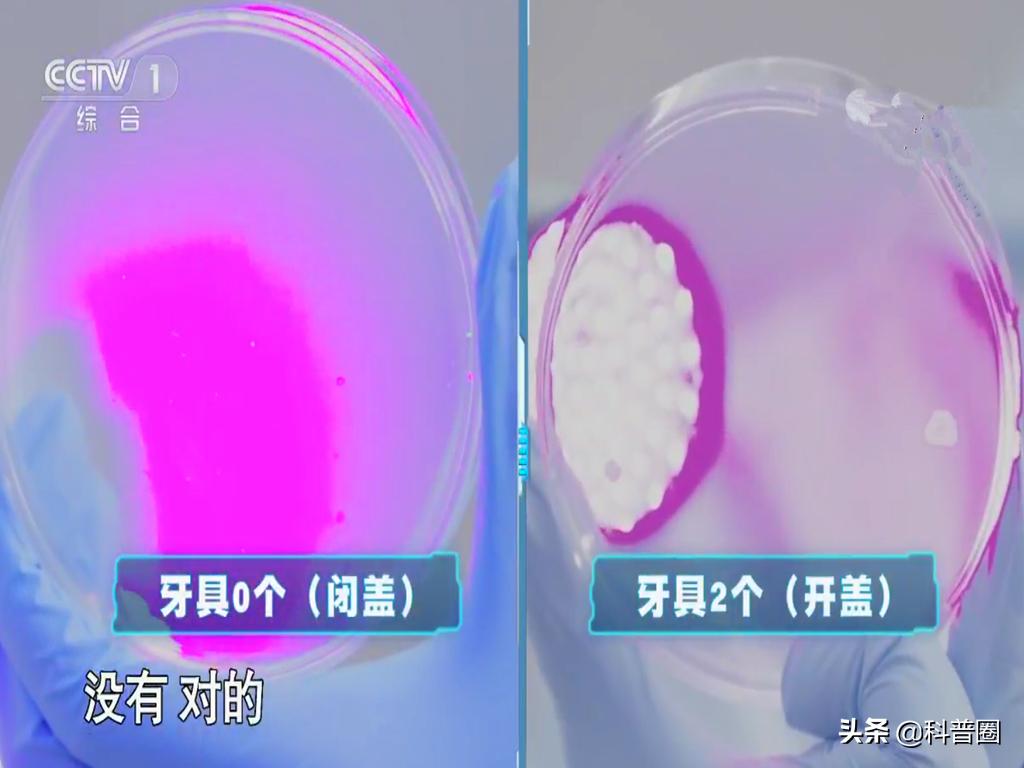
冲马桶时要不要盖盖子央视辟谣,冲马桶盖盖子和不盖盖子对比
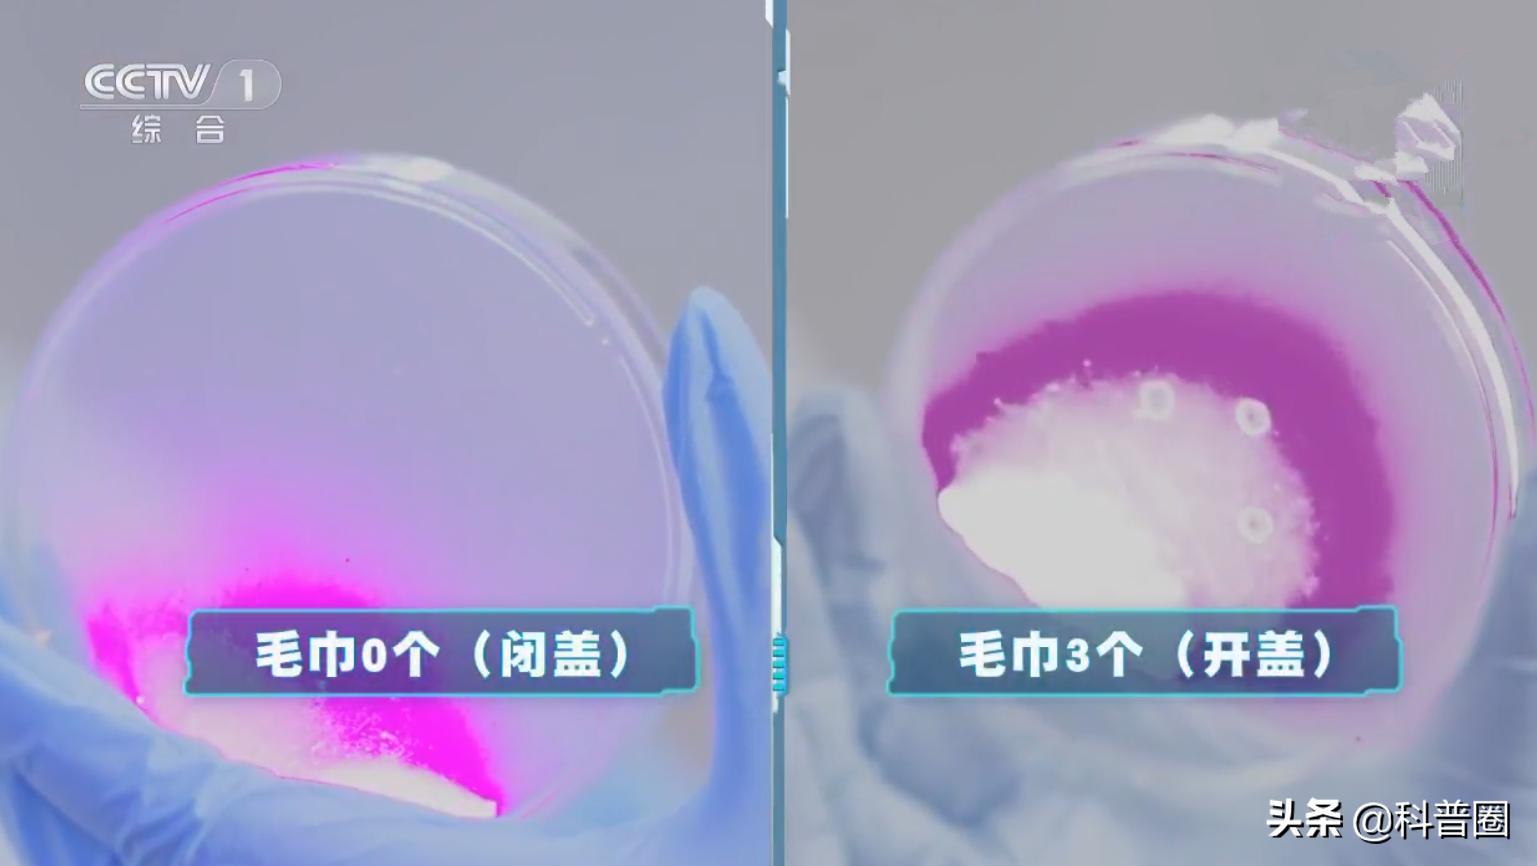
冲马桶时要不要盖盖子央视辟谣,冲马桶盖盖子和不盖盖子对比
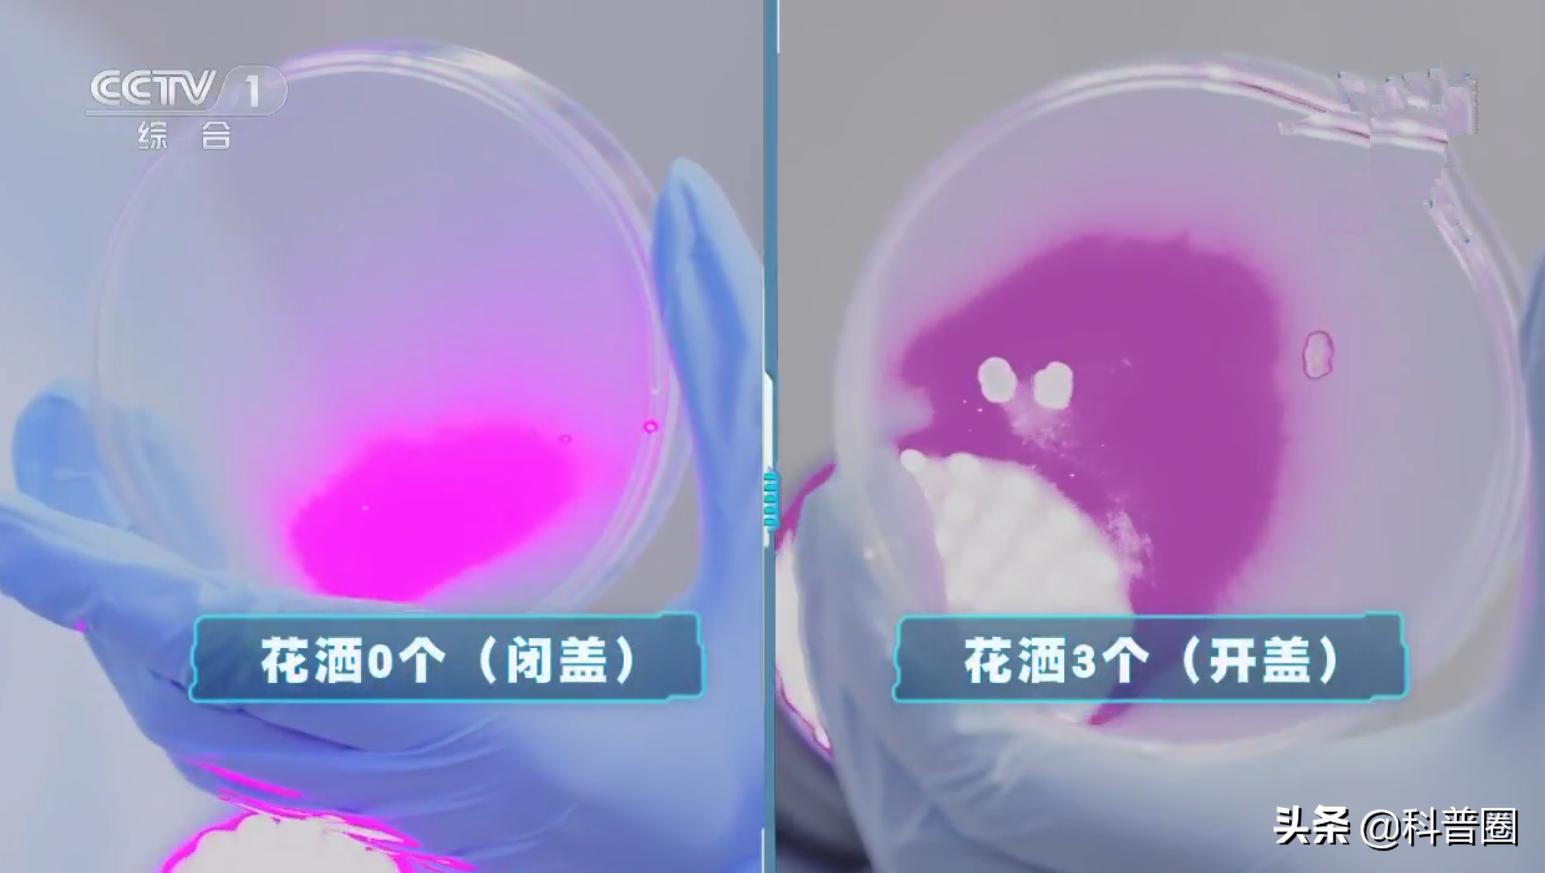
冲马桶时要不要盖盖子央视辟谣,冲马桶盖盖子和不盖盖子对比
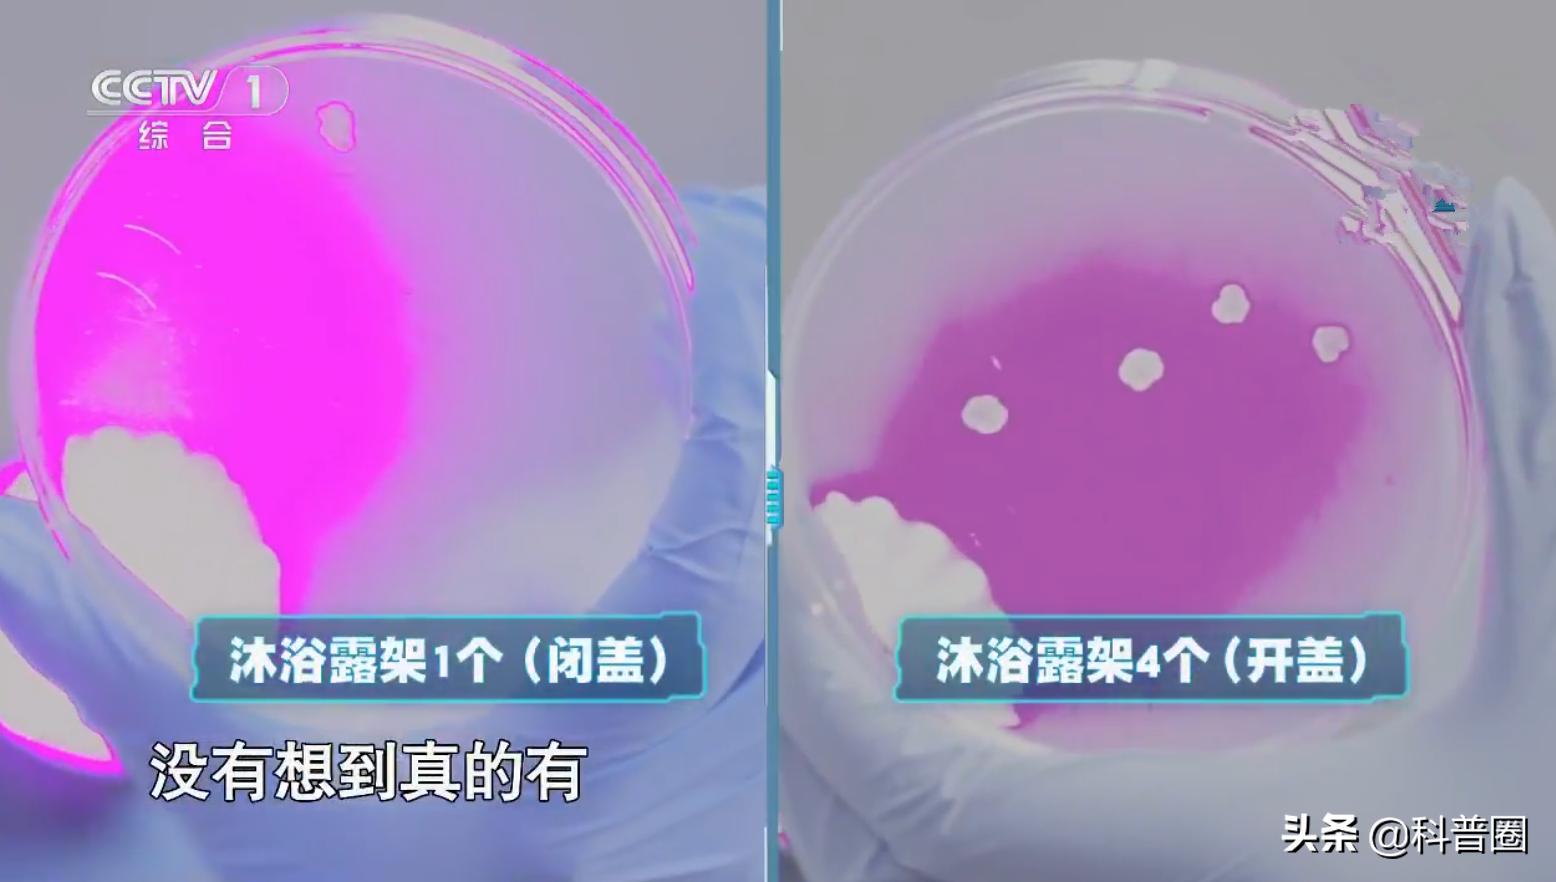
冲马桶时要不要盖盖子央视辟谣,冲马桶盖盖子和不盖盖子对比
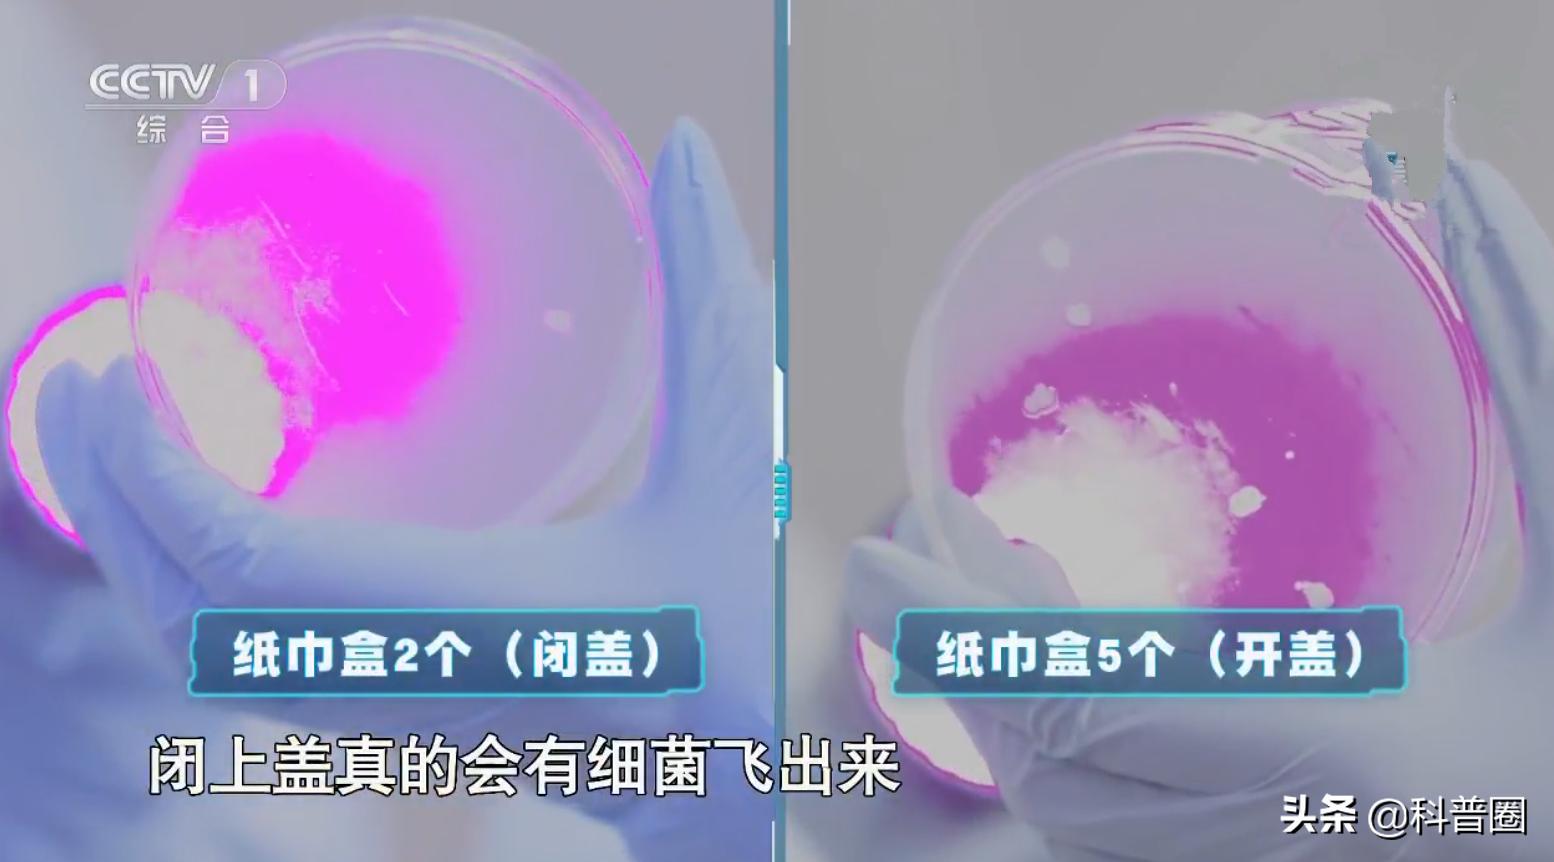
冲马桶时要不要盖盖子央视辟谣,冲马桶盖盖子和不盖盖子对比
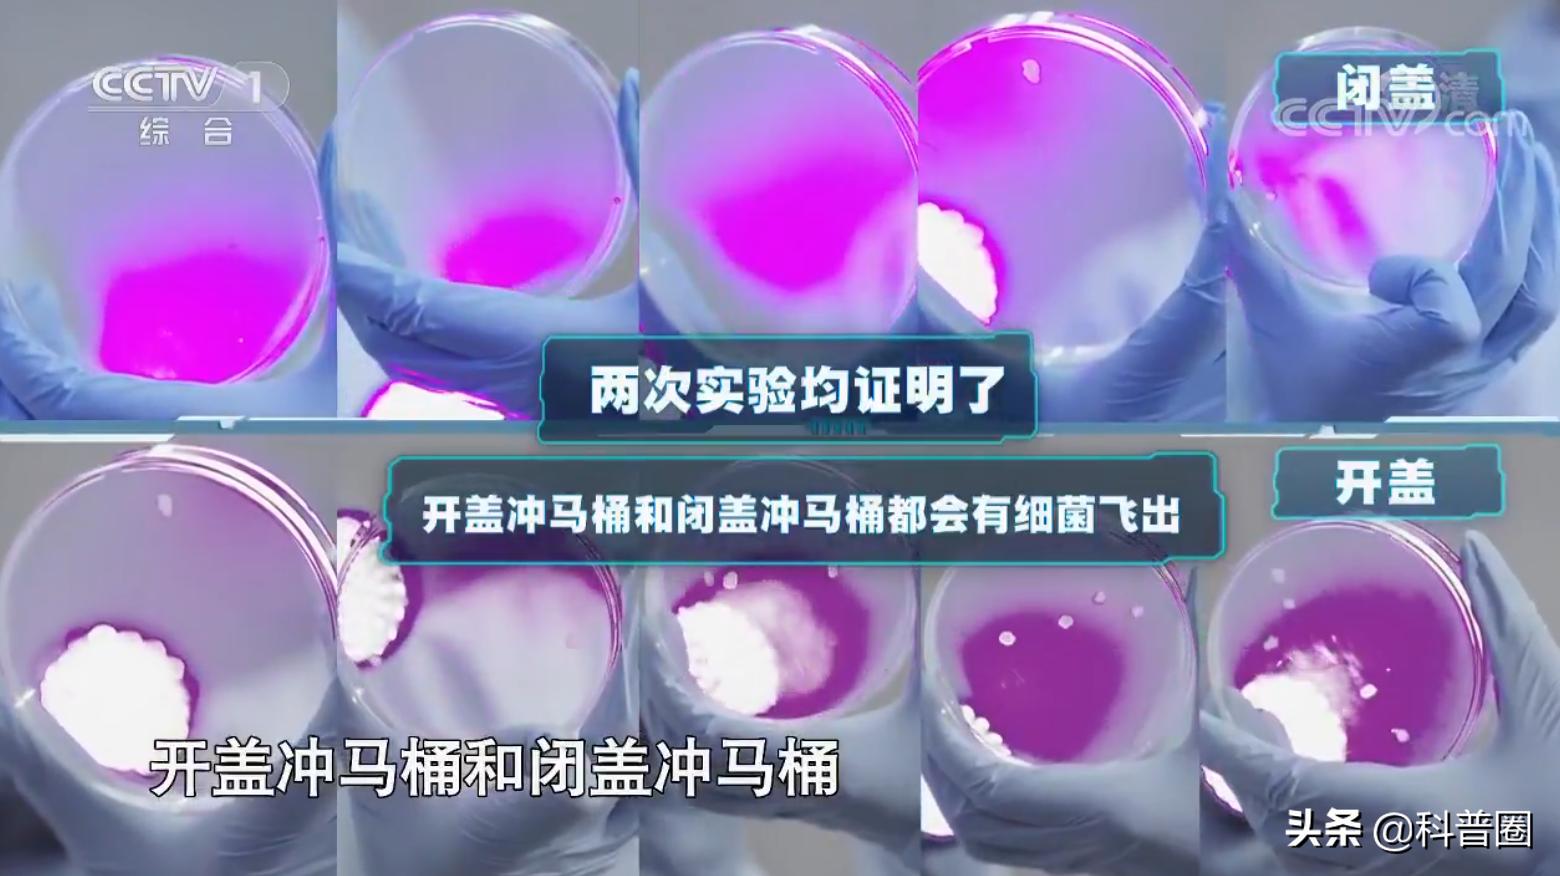
冲马桶时要不要盖盖子央视辟谣,冲马桶盖盖子和不盖盖子对比
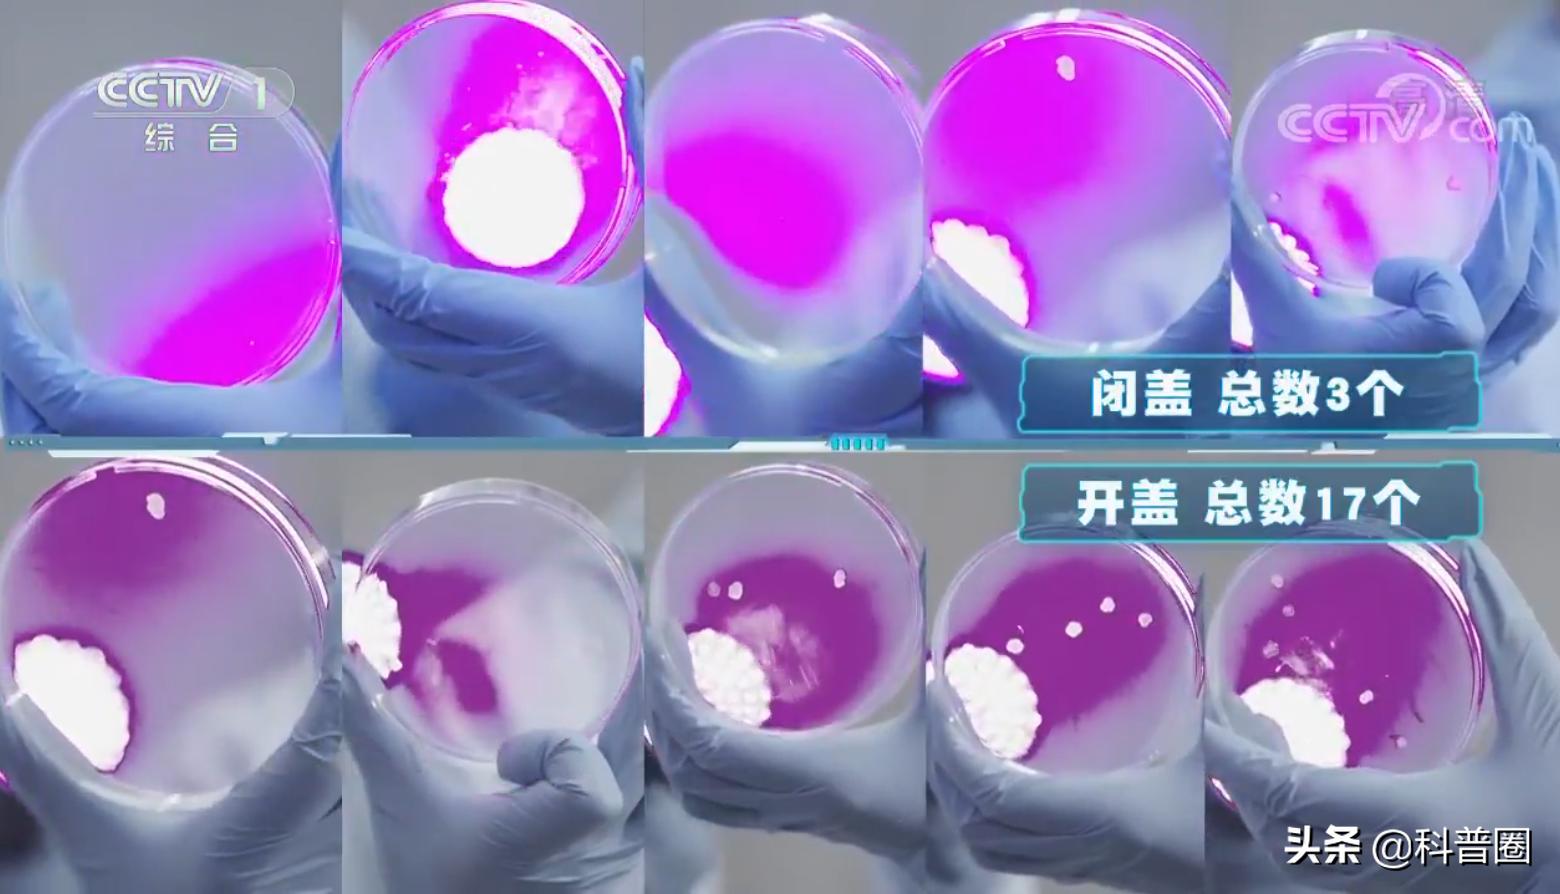
冲马桶时要不要盖盖子央视辟谣,冲马桶盖盖子和不盖盖子对比

根据世界厕所组织的调查报告,每个人每天进出厕所6-8次,其中一次大约为5分钟,而余下的每次平均为2分钟。

这样算下来,人一生当中大概有2年的时光在厕所里度过。
如今不少人家里的厕所都用上了抽水马桶,比蹲厕更加舒适。然而,生活中存在这样一种说法:“ 冲马桶时一定要把盖子盖上,不然对身体有害”。

纽约大学菲利普·泰尔诺博士指出,如果冲水时马桶盖打开,马桶内的瞬间气旋最高可以将病菌或微生物带到6米高的空中,并悬浮在空气中长达几个小时。

更可怕的是,研究结果表明,马桶内溅出的病菌还会落在厕所墙壁和物品上,例如牙齿、漱口杯、毛巾等,甚至还可能会趁机进入人体口腔和呼吸道。
日常生活里,许多人“解决问题”后,大多是直接按下冲水按钮,并没有盖上盖子再冲的习惯。

看到上面观点,不少人吓坏了,甚至都有了阴影,总觉得冲马桶时不盖上盖子,会有很多污染物飞溅喷射出来,到处都充满了细菌。
那么,冲厕所时,到底要不要盖上盖子?不盖上马桶盖,真的有那么严重吗?
冲马桶,盖?还是不盖?
根据调查发现,32%的马桶上有痢疾杆菌,其中一种名为“宋内”的痢疾杆菌能在马桶圈存活长达17天。
还有一份实验报告指出,将一亿个脊髓灰质病毒投入马桶内,溅到座圈上的病毒竟然高达3000个。

如此看来,人们皮肤接触最“亲密”的马桶,不盖上盖子冲厕所污染这么严重,很有可能成为疾病之源,这岂不是很可怕?

有人曾用紫外线显色颜料和高速摄像机,拍下了马桶开盖冲水的瞬间,在离心力的作用下,发现马桶内的污染物可以喷射到60cm高处,在1.8米外的牙刷上也遭到了污染。

这令人恐慌不已,不盖上盖子冲马桶,竟然存在这么大的健康风险?央视一档节目《加油!向未来》通过实验来探究“开盖闭盖冲马桶,到底有没有区别”。

实验里,中科院微生物研究所的研究员利用“荧光细菌”充当人体的排泄物,并将5个收集细菌的培养皿分别放置在卫生间的牙刷架、毛巾、纸巾盒等处,然后静置48小时。。
- 第一组实验:检测开盖状态下冲水,细菌散播情况
研究人员检测5个培养皿中的细菌情况,发现在开盖下冲水,真的会有细菌溅出,并且离马桶越近,细菌数量就越多。
- 第二组实验:检测闭盖状态下冲水,细菌散播情况
实验结果令人大吃一惊,闭上马桶盖冲水,也会有细菌喷射出来。不过相比第一次开盖冲水,细菌飞出来的数量明显减少了。

- 第三组实验:对比开关盖两种状态下冲水,马桶周围细菌散播情况
两次实验结果证明,开盖冲马桶和闭盖冲马桶,都会有细菌飞出。
而后者细菌总数会减少:开盖冲马桶,培养皿收集到的细菌总数为37个;闭盖冲马桶,培养皿收集到的细菌总数为16个。
可见,由于马桶本身并不是完全密闭的,冲马桶无论盖还是不盖,细菌都有可能冲出,不过闭上盖确实能减少一定的潜在风险。
微生物不同,扩散范围也不同
人体排泄物除了有食物残渣、脱落的细胞之外,还有许多细菌、病毒、甚至寄生虫等。
一项研究发现,由于微生物本身的特性,并不是所有的细菌都能借助抽水气旋传播到空气里,气旋威力的大小影响着微生物的传播范围。

例如,有实验显示,大肠杆菌在冲水后的2小时内,分布在以马桶为中心直径约1米的范围,而沙门氏菌则仅需要30分钟。

更重要的是,马桶类型的不同,抽水气旋威力的大小也不同。
从冲水方式划分,目前市场上的马桶主要分为两类:虹吸式马桶和直冲式马桶。

虹吸式马桶利用压力差将污物吸走,噪音更小,冲水时会发出“吨吨吨”的声音;而直冲式利用水落下时产生的冲力冲走污物,瞬间产生的气流比较大,冲水噪音也更大。

实验数据显示,虹吸式马桶冲水时,带起的微生物大约只有直冲式的1/14。 目前国内许多家庭大多也是选用“虹吸式”。
结语
专家表示,从已有的研究结果来看,马桶冲水时的气旋,确实能造成微生物的传播,可能会对人体健康造成影响。但传播的范围、时长尚未明确知晓,能否致病还有待进一步研究。

其实,我们本身就是生活在一个有菌的环境里,不过大多数微生物是无害的,只有少部分会致病。另外,无论哪一种微生物想要致病,都需要有一定的“致病剂量”。

因此,我们需要警惕通过马桶气旋传播的微生物,但无需过度恐慌或者感到焦虑。

建议大家冲马桶时,应养成盖上马桶盖的习惯,定期消毒和清洁马桶。与此同时,还要注意马桶圈的清洁,经常开窗通风,保持卫生间清洁干燥。
那么看完这篇文章,冲马桶时,你是选择盖?还是不盖呢?
---END--